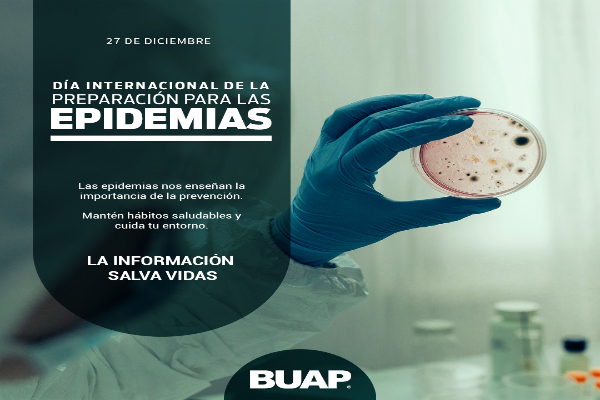

La BUAP conmemora el Día Internacional de la Preparación ante las Epidemias
La Benemérita Universidad Autónoma de Puebla (BUAP), por medio de sus redes sociales, se suma a la conmemoración del Día Internacional de la Preparación ante las Epidemias. Esta fecha instaurada por la Asamblea General de la Organización de Naciones Unidas (ONU), desde el 2020, denomina el Día Internacional de la Preparación ante las Epidemias el 27 de diciembre. Este […]
Accidente en la autopista Perote-Xalapa deja 7 muertos y 10 heridos

Un trágico accidente entre un autobús de pasajeros ADO GL y un tráiler dejó un saldo preliminar de siete personas fallecidas y diez lesionadas en la autopista Perote-Xalapa, a la altura del kilómetro 108, en el paraje conocido como Los Molinos o Cerro de León. El autobús, que salió de la Ciudad de México con […]
CECyTE Puebla promoverá desarrollo integral del alumnado

Rindió protesta Estebini Fernández como directora general de la institución Al rendir protesta como directora general del Colegio de Estudios Científicos y Tecnológicos del Estado de Puebla (CECyTE), Estebini Fernández manifestó su compromiso de fortalecer la educación técnica de calidad y promover el desarrollo integral de las y los estudiantes que forman parte de éste […]
La BUAP convoca a su Maestría en Antropología Sociocultural

La Benemérita Universidad Autónoma de Puebla (BUAP), convoca a las persona interesadas a cursas la Maestría en Antropología Sociocultural, a través del Instituto de Ciencias Sociales y Humanidades“Alfonso Vélez Pliego”. Dando como fechas para la recepción de documentos del 15 de enero al 15 de marzo de 2025. Para más información, consulta la convocatoria aquí: https://ow.ly/5tTk50Uxqyk […]
Se mantiene cierre total en la autopista Puebla-Córdoba por deslave

La autopista Puebla-Córdoba permanece cerrada en ambos sentidos a la altura del kilómetro 231+100, en dirección a Puebla, debido al deslave de talud que cubrió por completo la carpeta asfáltica. Autoridades viales informaron que continúan los trabajos en la zona para restablecer la circulación, hasta el momento se tienen habilitadas rutas alternas para garantizar el […]
Congreso del Estado de Chiapas aprueba el matrimonio igualitario

En la sesión de este jueves, las y los legisladores avalaron las reformas al Código Civil que permiten a todas las personas contraer matrimonio, sin importar su orientación sexual. “Aquí no estamos para prohibir. Bienvenida la Nueva Era y con ello bienvenidas estas reformas con las que se atienden las demandas sociales y que hacen […]